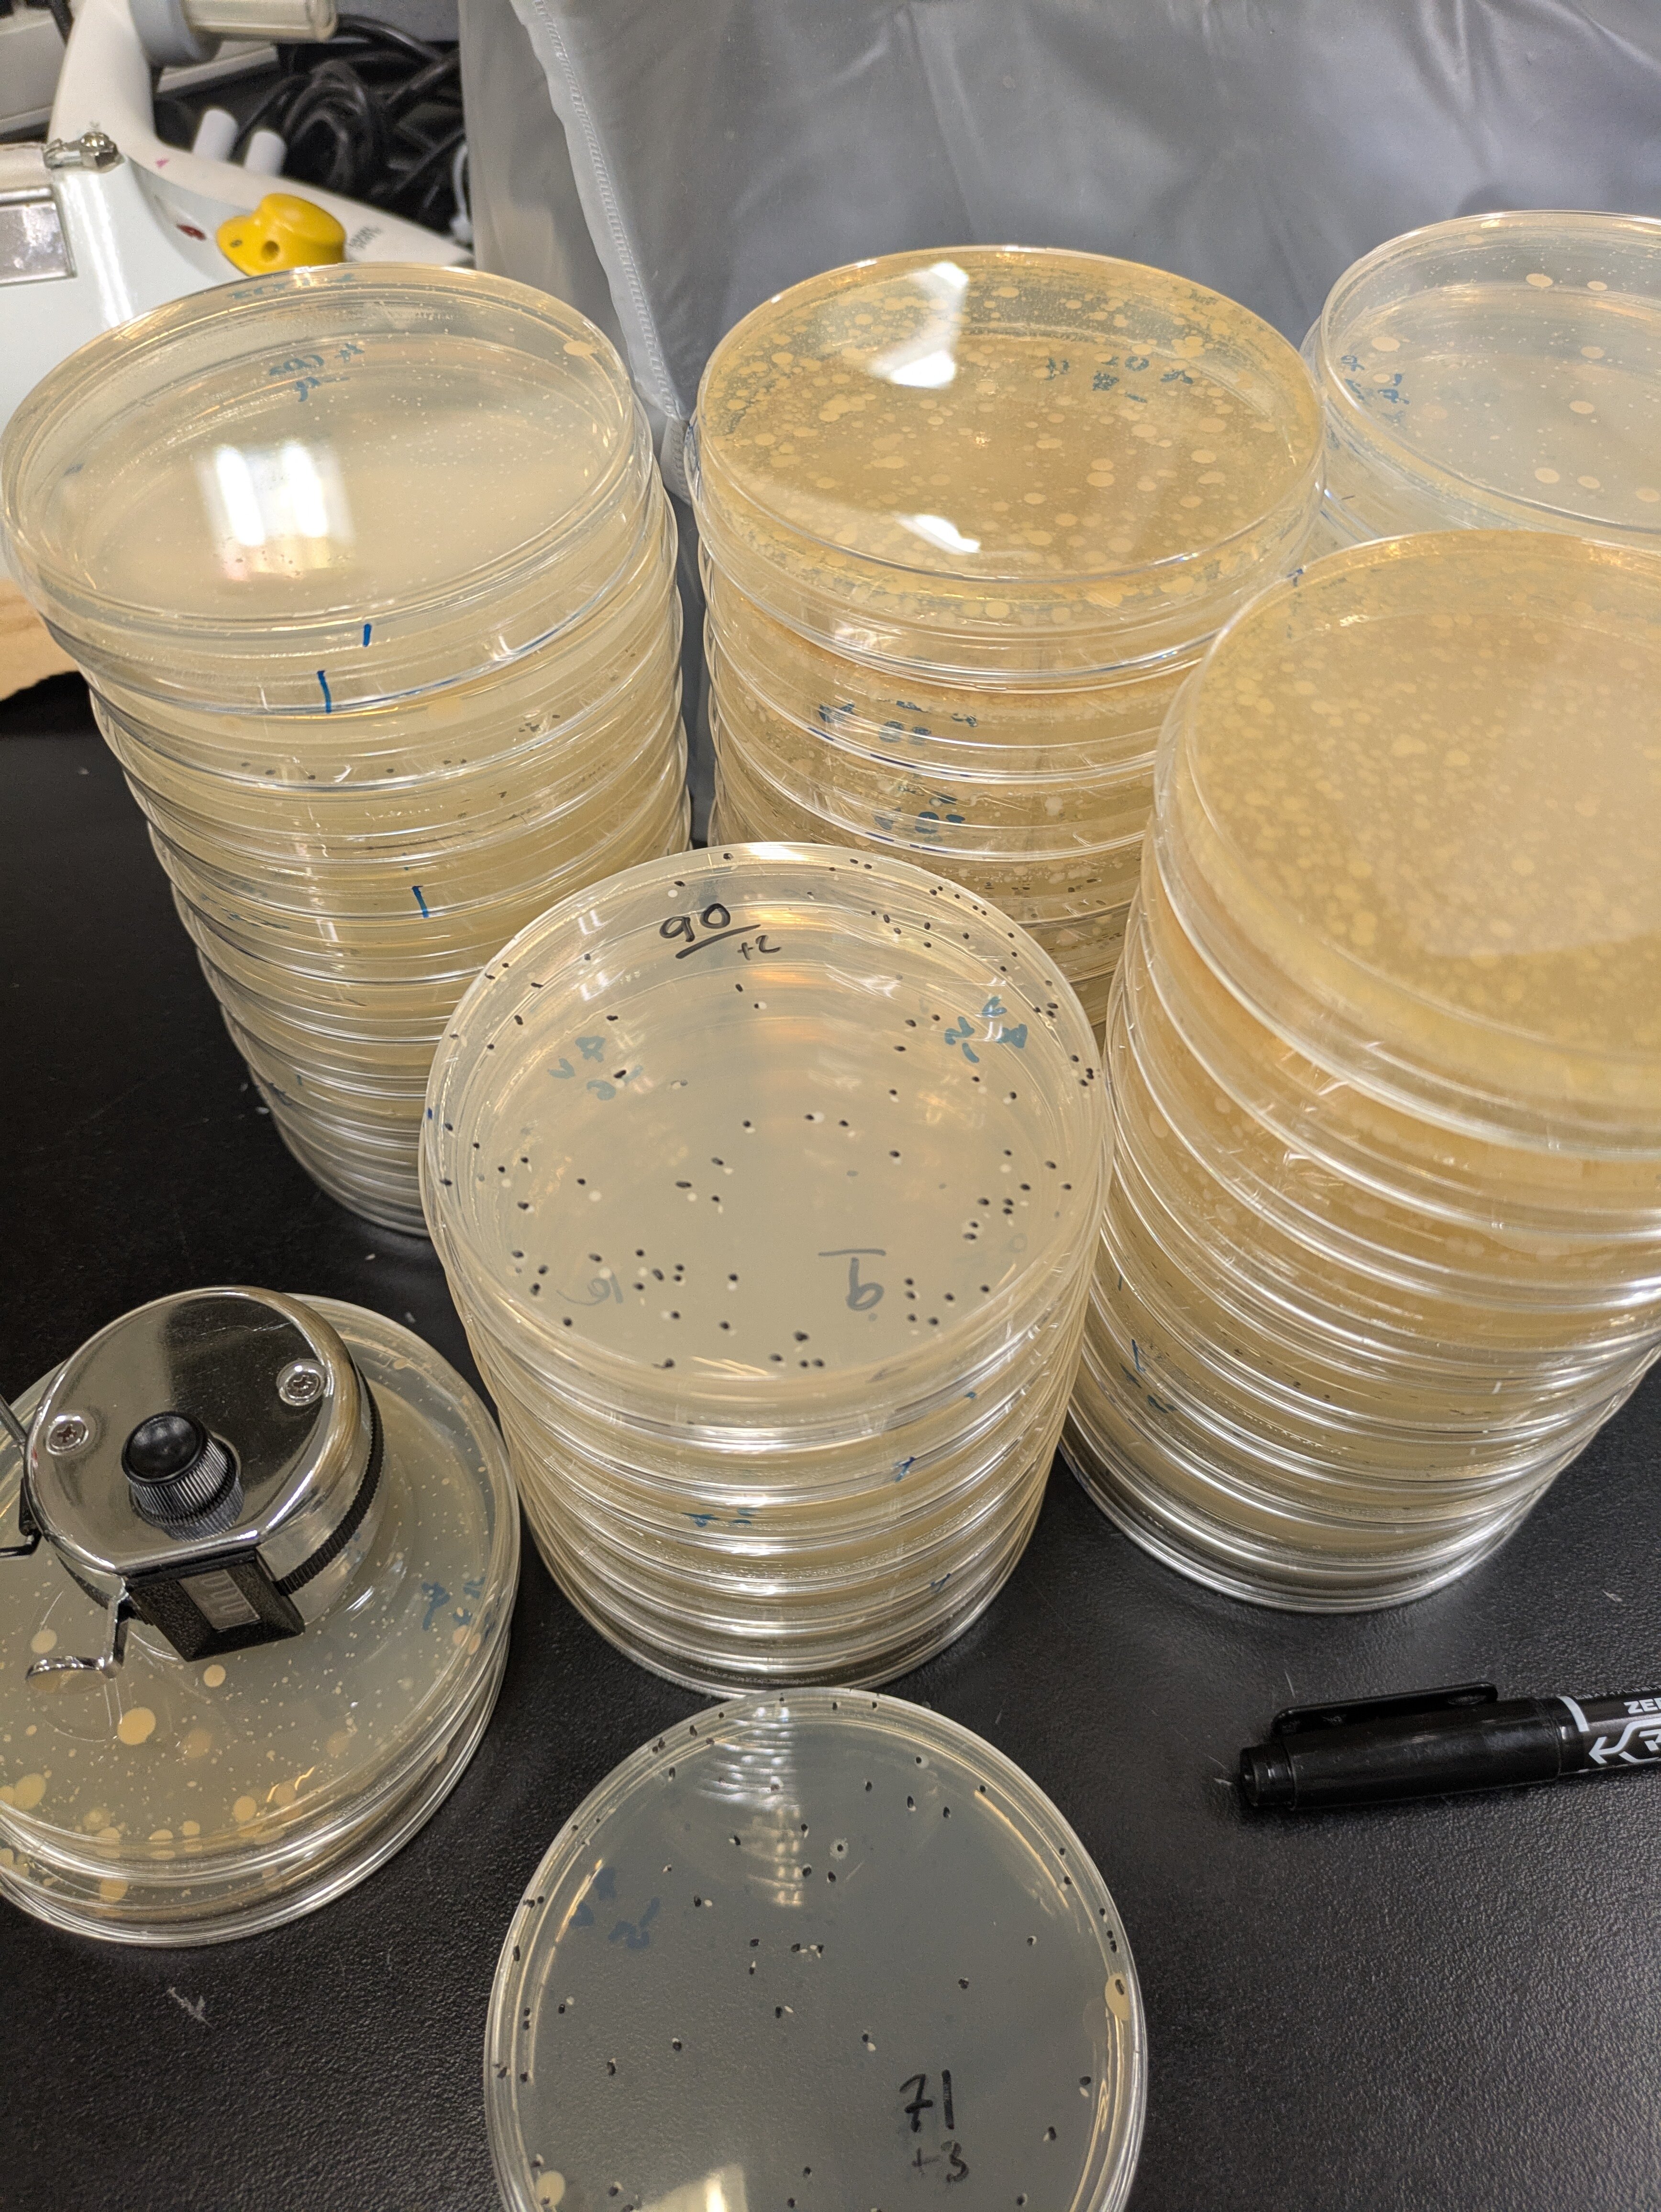

CTEX Participation 2025 April -2025 August
Master student, Biotechnology,
Norwegian University of Science and Technology (NTNU), Norway
M. N.
I'm a master student at the Norwegian University of Science and Technology (NTNU), and I am doing an integrated masters in biotechnology (5 years masters with no bachelor). My masters project is about Listeria isolated in Japan and Norway, and is a collaboration between TUMSAT and NTNU. The opportunity to visit Japan was a big consideration for me when choosing the project, and luckily I was approved and granted the opportunity to work under professor Hajime Takahashi and assistant professor Ayaka Nakamura at TUMSAT. In total I stayed at the Shinagawa Campus for a semester ( April-August).
The university semesters start in different parts of the year in Norway and Japan, and the study setup also differs, so I was a bit confused in the beginning. Luckily I received a lot of guidance and help from Tomoko-san (METIS coordinator) regarding the application process and preparations. I chose to mainly work on my masters project, but in addition take two courses, as well as the voluntary Japanese course offered by TUMSAT (without credit). Compared to Norway, the courses in Japan were smaller with less credits and the lab work was more independent. One thing which was quite different in Japan and which I enjoyed a lot was the community around the lab, which was very tight knit and friendly. I also found the work culture in Japan quite formal compared to home, and everyone stayed at the university until 17 most days, but I got used to it pretty quickly.
In addition to all the help from Tomoko-san, I also got a lot of help from my mentor (Komori-san), who helped with my general life in Japan and adapting to life in the country. I had to absorb a lot o information and do a lot of paperwork when I first arrived in Tokyo. I needed help with the dormitory registration, creating a bank account and a lot of paperwork at the city hall. I am eternally grateful to Komori-san who agreed to become my mentor and helped me, as I would have been extremely lost by myself. Most of the paperwork was only available in Japanese and not many people were fulent in English, but due to the METIS and mentor programmes, I felt welcomed and got all the initial paperwork finished.
Day to day, I enjoyed my life in Tokyo a lot. I stayed at the dormitory on Shinagawa campus. I was put on the 5th floor with a beautiful view of the channel from my window and balcony. My room was supplied with everything I needed with a tiny kitchen, AC, bed, desk, cabinets and a separate toilet. Each floor had common washing machines, dryers and showers. The dormitories at campus were very cheap compared to elswhere in Tokyo and in Norway, in addition to making the morning commute very short and mangageable.
Another thing I enjoyed a lot about my stay was the food. In Norway dining out is very expensive , and is often only done on special occasions. In Japan eating at restaurants was way cheaper, and the food itself was super delicious. For me. the food was one of my best experiences in Japan. The canteen at Shinagawa campus was another highlight. It was super convenient, cheap and delicious, with freshly made food every day and variations in the menu every second week. It quickly became my go to to lunch spot.
My average week at TUMSAT would consist of Japanese lessons on Mondays and Fridays, while research and lab work would take up my remaining time. I participated in both Beginner Japanese and Rapid beginner Japanses lessons of which both were very fun and interesting . When I first came to Japan I could understand almost nothing, but when I left I felt like I had a basic understanding of the language. The Japanese classes also helped me make more friends from different parts of the world.
I participated in the Food Microbiology and METIS courses. The Food microbiology course was held along with the other first year master students in my laboratory. We took turns presenting different topics each week, while everyone else watched and wrote summaries. It was very insightful and relevant to my studies.
The METIS course was an intensive digital course taking less than two weeks. It was only two hours in the afternoon (morning in Scandinavia ) and covered various topics regarding marine science. Different professors from different universities participating in the METIS programme held the lectures covering everything from deep sea mining, cold chain food transport, biology around hydrothermal vents and much more. I really enjoyed the course and I feel it widened my view on marine science.
Aside from my studeis, I spent much of my free time traveling and sightseeing, both in Tokyo and other places in Japan. It was very easy and convenient to travel around. I ended up visiting the majority of the aquariums in Tokyo before going back, as well as some aquariums in other towns. I traveled some by myself and with new friends and some old friends that came visiting. My favoirte towns I visited were Beppu and Hiroshima.
All in all, my experience in Japan at METIS was an amazing experience , and I would highly recommend applying if you have the opportunity. I guarantee living in Tokyo for a whole semester is an experience you will never forget!